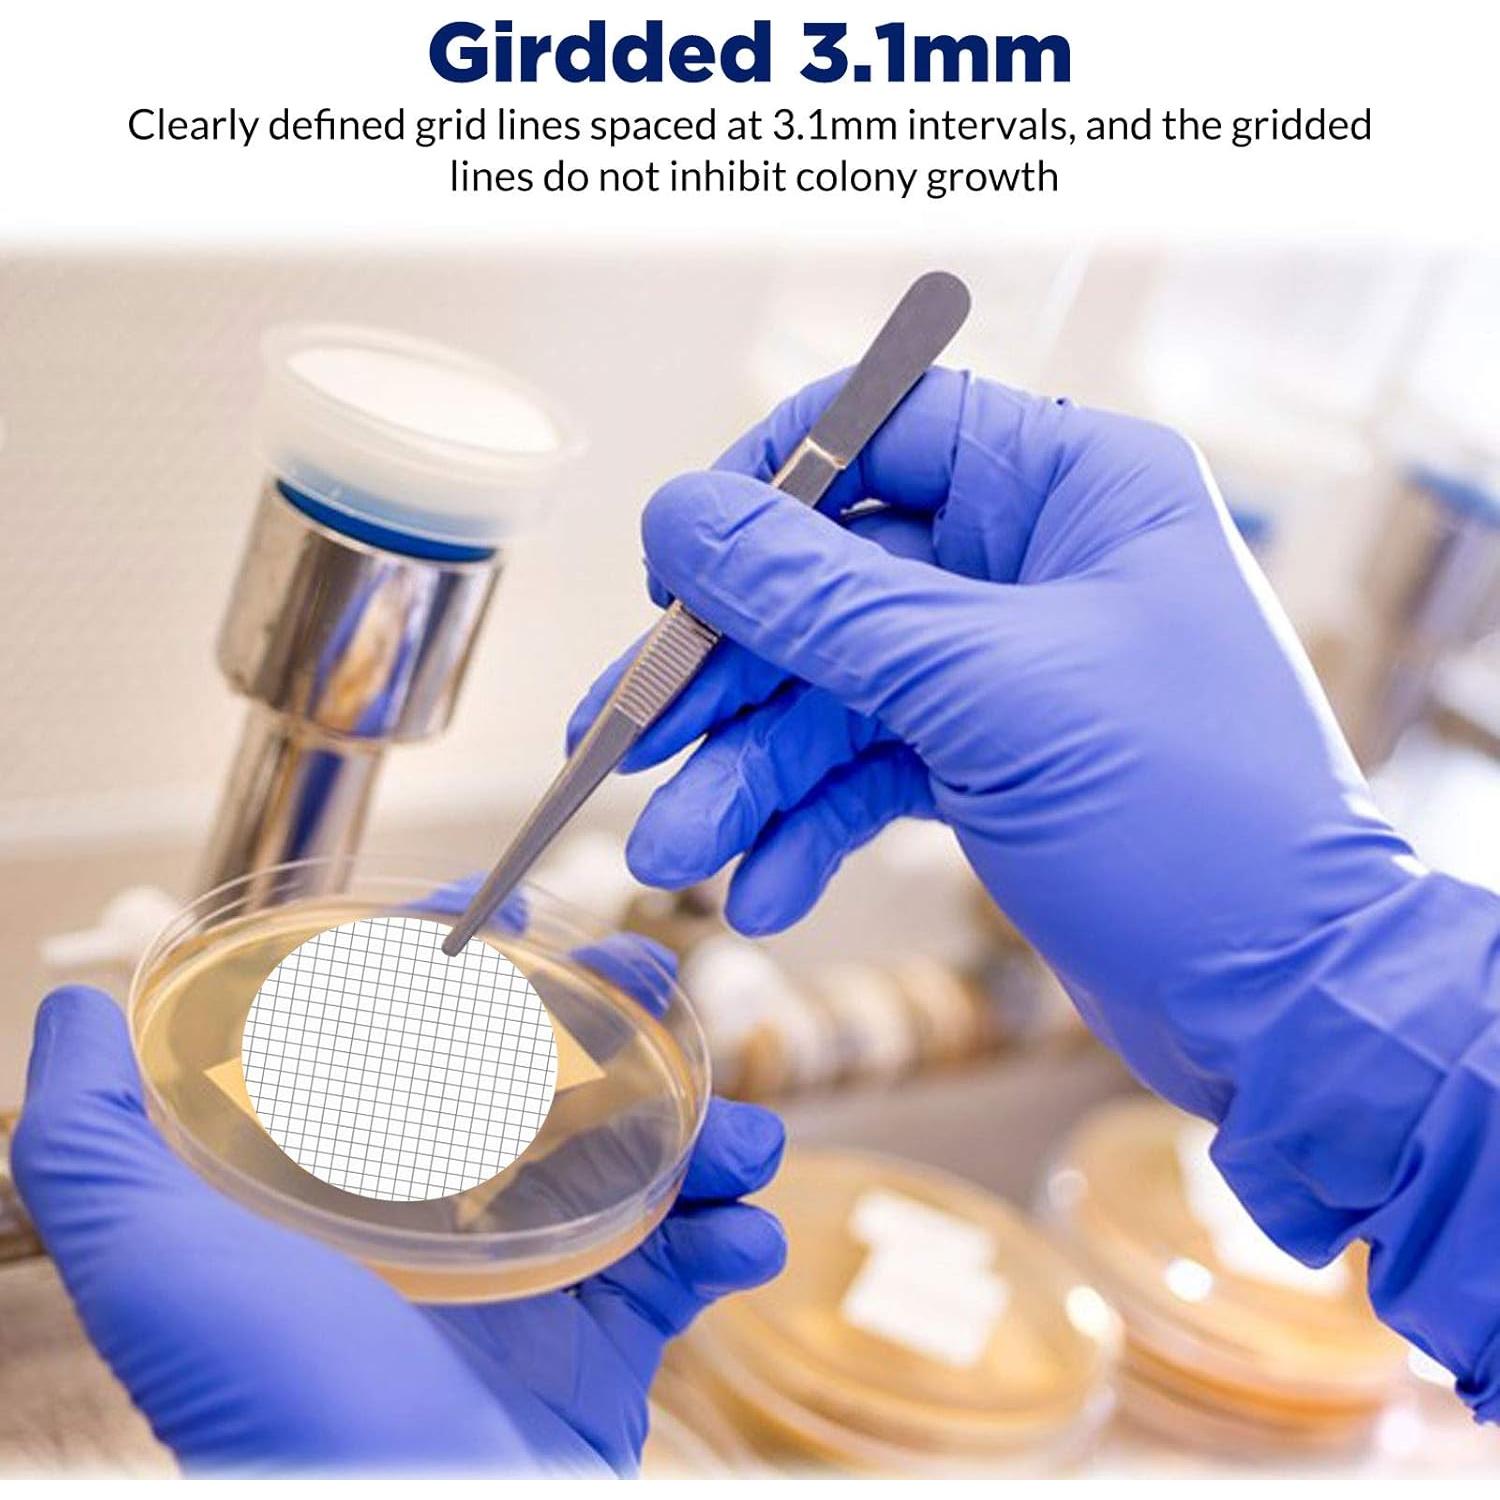
Filtro de Membrana MCE 47 mm 0.45 um Estéril 100 Unidades

Bay State Importers
Filtro de Membrana MCE 47 mm 0.45 um Estéril 100 Unidades

Filtro de Membrana MCE 47 mm 0.45 um Estéril 100 Unidades
$67.106
+ impuestos: $14.092
Llega a domicilio entre el 28 de ene y el 2 de feb
- Compra protegida
- Envío a todo el país
- Garantía de entrega
Características destacadas
- APLICACIÓN: El filtro de membrana de éster de celulosa mixta (MCE) está compuesto de acetato de celulosa y nitrato de celulosa, que es altamente biológicamente inerte y se utiliza ampliamente en el análisis microbiológico de agua, aguas residuales, cosméticos, productos farmacéuticos y bebidas.
- MEMBRANA DE ALTA CALIDAD: El filtro de membrana en cuadrícula estéril es una membrana naturalmente hidrofílica sin capa de soporte, ideal para el conteo de colonias y pruebas de esterilidad, y nuestra membrana MCE está certificada con ISO 9001 y cumple con los requisitos de ISO 7704.
- LÍNEAS DE CUADRÍCULA: Los filtros en cuadrícula tienen líneas de cuadrícula claramente definidas espaciadas a intervalos de 3.1 mm. Las líneas de cuadrícula contrastantes facilitan el conteo de colonias en la superficie del filtro y se prueban para asegurar la libertad de inhibición de las líneas de cuadrícula.
- ALTA POROSIDAD: El filtro de membrana microbiana tiene alta porosidad que permite que gases y líquidos proporcionen altas tasas de filtración en cada área. La alta porosidad también proporciona una gran superficie para adsorción y unión.
- PAQUETE INDIVIDUAL ESTÉRIL: Los filtros de disco de membrana están esterilizados por radiación gamma de 25 kGrey, sellados de forma estéril sin papel protector, colocados en una banda en paquetes individuales. Esta configuración especial asegura que cada filtro de membrana se mantenga perfectamente plano cuando se dispensa.
- Nota: El producto no es capaz de esterilización; se suministra como estéril tras el procesamiento por irradiación.
Opiniones de compradores
53 opiniones
CETEC Laboratory
Excelente precio. Enviado rápidamente. Volveremos a comprarles.
John Jacobi
Encajan perfecto, funcionan genial. Me encanta que vengan sellados individualmente.
Tracy Simmons
¡Son geniales! Los pedí para un proyecto que está haciendo uno de nuestros estudiantes de investigación. Son fáciles de usar y el embalaje es bueno.
J. R.
Estos filtros son del tamaño perfecto y las rejillas facilitan que mis estudiantes cuenten las bacterias.
Joe F
Papel. No transpirable. Cero filtración. Podría hacer círculos en el papel, recortarlos y venderlos si no tuviera conciencia. ¡Qué vergüenza!
Descripción
Filtro de Jeringa PES
Tuberías de Centrifugado de 15 mL
Tuberías de Centrifugado de 50 mL
Especificaciones técnicas
- Fabricante
- Membrane Solutions Corp
- Dimensiones del producto
- 10.00 x 10.00 x 4.00 cm; 81.65 gramos
- Número de modelo del artículo
- MFMCE047045GWS
- Está descontinuado por el fabricante
- No
Preguntas y respuestas
Tu pregunta fue enviada. Te responderemos pronto.
¿Dónde te enviamos la respuesta?
Tus preguntas
· Recibirás la respuesta a




